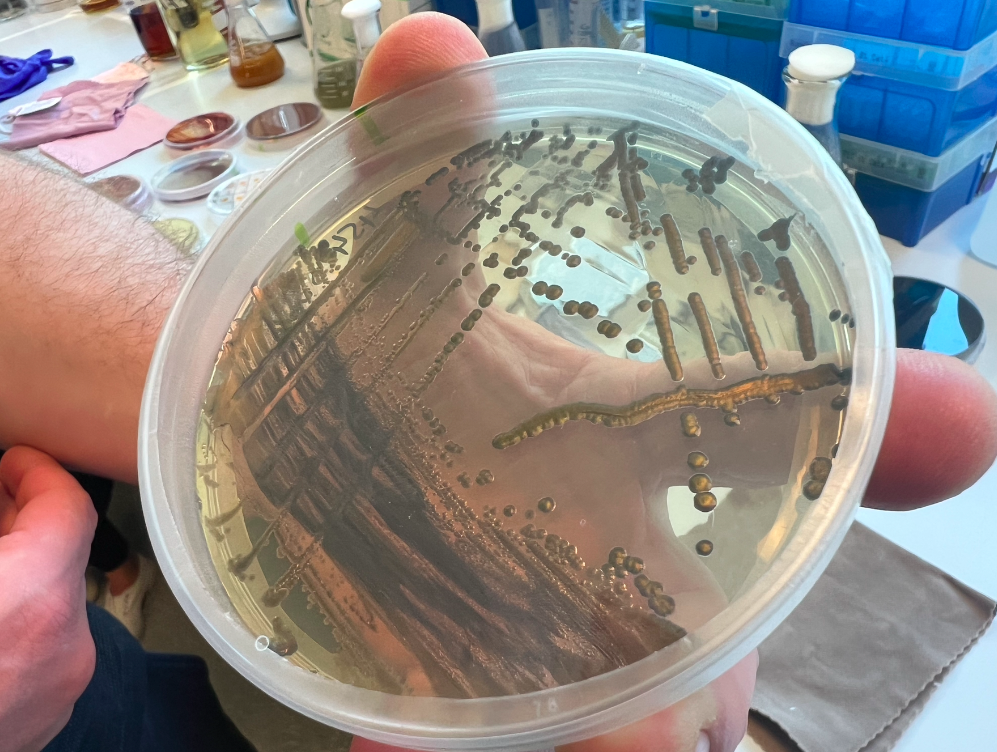

FABRIC: Violocein Dye, Colorfix
Regions: Norwich, England
Fabric Name:
Violocein dye
Origin: Microbes
Who made our dye:
Colorfix
Natural history and ecology:
For thousands of years, we have used natural pigments; but in the industrial age, natural dyes were quickly out-competed by synthetic dyes in cost, scalability, and performance. At Colorifix, they are circling back to nature and once again finding inspiration in its diverse palette. This time, however, they can do so without ever harming the environment, compromising on quality, or relying on supply chain availability.
What makes this so special:
Colorifix minimises the environmental impact of industrial dyeing by replacing chemistry with biology at every step in the process, from the creation of the dyes to their fixation into fabrics.
“Going back to nature.”
The science of sustainable colour…

“ We realized where the problem was taking place. When were all these chemicals going into the supply chain and for what purpose? And a lot of them had to do with putting color into fabrics. And we just thought that there must be a better way of doing that.”
-Orr Yarkoni/Violocein dye

Orr Yarkoni
The Colorfix began with Orr and his colleague Jim Ajioka--both synthetic biologists--learning of the dyeing industry’s impact on human health while working on the development of biological sensors that picked up metal contamination in water in Nepal. Colorfix’s process was conceived into a matter of steps: find a color in nature, identify and create a DNA code, engineer microbes to make color, send the microbes to the dyehouse, grow color through fermentation, and apply the dye using standard machinery. The process eliminates the unnecessary environmental harm that is characteristic of the traditional dye industry. Colorfix uses biology to replace chemistry both in the making and fixation of the dyes. The fascinating process determines how natural organisms produce certain colors and replicates those genes in their own engineered microorganisms. The microorganisms will produce the colors they were made to create. Colorfix’s microorganisms are renewable feedstocks and divide every 20 minutes, allowing a large quantity of colored dye to be produced within a day or two. The methodology serves not only fashion brands and manufacturers, but also creates an environmental benefit.